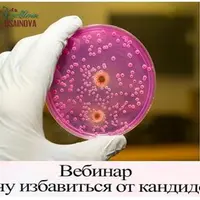
Хочу избавиться от кандидоза

Курсы и материалы автора

Мой здоровый желчный пузырь
Алина Усаинова
Как избавиться от 90% сбоев в работе организма
Алина УсаиноваГипоацидность и его коррекция
Алина Усаинова
Covid 19. Готовь сани круглогодично!
Алина Усаинова
Узнай, усваивается ли твоя еда!
Алина Усаинова
Мой плоский живот
Алина УсаиноваЗдоровый ЖКТ - основа твоего здоровья
Алина Усаинова
Грипп, ОРЗ, Коронавирус. Как защитить себя?
Алина Усаинова
Как восстановить ДЕТОКС?
Алина Усаинова
Научись читать свои анализы
Алина Усаинова
Хочу избавиться от кандидоза
Алина Усаинова
Хеликобактер пилори. Друг или враг?
Алина Усаинова
Нарушение детокса и синдром Жильбера
Алина Усаинова
Как снизить плохой холестерин. Часть 2
Алина Усаинова
Как снизить плохой холестерин. Часть 1
Алина УсаиноваРазбор анализов пациента. Часть 3
Алина УсаиноваПриведи давление в норму
Алина Усаинова
Всё о витаминах
Алина Усаинова
Выбор витаминов и минералов. Важность их правильного сочетания между собой. Часть 1
Алина УсаиноваКлинический разбор анализов 4
Алина УсаиноваПроблемы ЖКТ: СИБР, СИГР, СРК. Причины, диагностика, коррекция. Микробиота кишечника. Часть 2
Алина УсаиноваКлинический разбор анализов. Часть 3
Алина Усаинова
Разбор реальных анализов
Алина УсаиноваОтзывы 20
− Упражнения показываются в закрытой одежде, из-за чего информация считывается плохо и требуется много времени, чтобы понять технику выполнения.
Мой плоский живот+ Курс очень объемный и подробный. Автор использует интегративный подход: разбирает симптомы и причины их возникновения, предлагает разнообразные инструменты для работы с патологиями. Информация подана доступно.
− Из-за акцента и неправильного произношения слов автором смысл сказанного иногда терялся, приходилось перематывать видео назад.
Здоровый ЖКТ - основа твоего здоровья+ Механизм описан подробно.
− Рекомендации по лечению и БАДам вызывают вопросы. Автор не объясняет причины выбора конкретных БАДов и не приводит ссылки на исследования. Также в открытых источниках есть противоречивая информация о влиянии некоторых продуктов, например кофе и зелёного чая.
Нарушение детокса и синдром Жильбера+ Доктор объясняет всё очень подробно: механизм развития синдрома, необходимые обследования, добавки (что принимать, а что может ухудшить ситуацию) и вопросы детокса в целом. Курс очень полезный, к основному материалу добавлены бонусы.
Нарушение детокса и синдром Жильбера+ Материал качественный.
− Курс лучше проходить после первой части, так как много отсылок, которые затрудняют понимание. Иногда отвлекают посторонние звуки.
Всё о витаминах+ Материал объемный.
− Лектора очень скучно слушать, нет видеоряда. Много пауз, слов-паразитов («так», «ну», «вот»). Создается впечатление, что автор не готовилась к вебинару и была не знакома с содержанием слайдов.
Выбор витаминов и минералов. Важность их правильного сочетания между собой. Часть 1+ Автор закрыл вопросы по наиболее биоактивным формам, сочетаемости добавок и времени их приёма. Информация поможет справиться с симптомами дефицита и сопутствующими заболеваниями.
− Необходима предварительная работа с ЖКТ, иначе усвоение минералов и витаминов будет неэффективным.
Всё о витаминах+ Содержание лекции неплохое, подача материала достаточно подробная.
− Мало информации о витаминах, упор сделан только на минералы. В середине лекции есть проблемы со звуком, последние 20 минут отсутствует изображение (темный экран), из-за чего не видны слайды с минеральными комплексами. Автор лекции просто читает текст с экрана очень медленно.
Выбор витаминов и минералов. Важность их правильного сочетания между собой. Часть 1